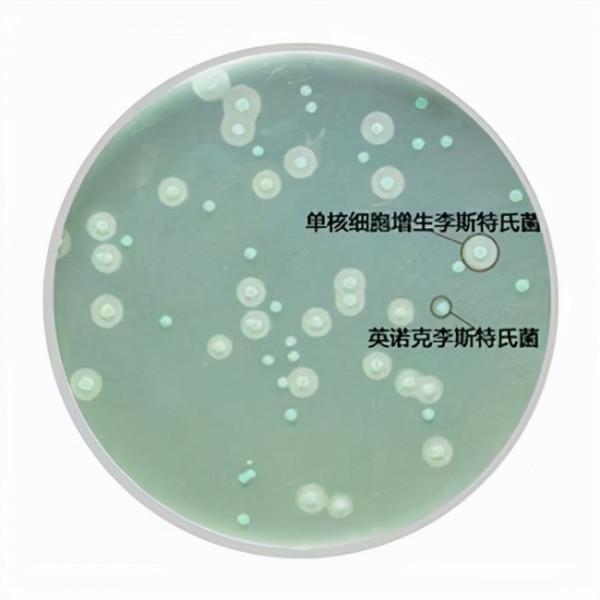
食源性致病菌,原來是你在搗亂 食源性致病菌,原來是你在搗亂

最近,新聞上頻頻出現“某男子連續食用過期食物導致住院”等和食物相關的熱點。古今中外,食品都是人類生命活動的基礎。現如今,人民生活富足,不再像以前只追求量,其質是更為重要的,與此同時,人類的腸胃環境也悄悄發生了一些變化,為了適應現在的飲食習慣和節奏。
“食源性疾病,是指有毒有害物質(包括生物性病原體)透過食物途徑進入人體所造成的疾病。而其首要因素就是致病菌,由其汙染而引起的食源性疾病危害遠遠超過違法濫用新增劑、農藥殘留等食品化學性汙染,是食品安全的重大隱患,也是食品安全的重要問題之一。”
“食源性致病菌(foodborne pathogen)是指以食物為載體而導致人類發生疾病的一大類細菌。包括大腸桿菌、沙門氏菌、金黃色葡萄球菌、單核細胞增生李斯特氏菌、志賀氏菌等。目前由食源性致病菌引起中毒的報告起數和中毒人數一直佔很高比例。”
我國的食品微生物汙染事件頻發,最常見的5種致病細菌是:沙門氏菌、金黃色葡萄球菌、副溶血性弧菌、阪崎腸桿菌、單核細胞增生李斯特氏菌,汙染食品且符合我國國情和地域飲食特點。這些肉眼難以捕捉的微生物,只能靠專業裝置才能檢測出來。平時民眾只能防患於未然,做好食品安全的日常基礎工作。牢記“保持清潔、生熟嚴分、葷食熟透、及時冷藏、拒絕過期”。
一、沙門氏菌(需氧及兼性厭氧菌)
沙門氏菌是一種常見的食源性致病菌,革蘭氏陰性腸道桿菌,屬腸道細菌科,包括那些引起食物中毒,導致胃腸炎、傷寒和副傷寒的細菌。1885年沙門氏等在霍亂流行時分離到豬霍亂沙門氏菌,故定名為沙門氏菌屬。沙門氏菌感染症為人畜共患感染性疾病,主要由食用遭受汙染的食物導致,是許多國家食物中毒的重要病源。該菌主要汙染肉類食品,魚、禽、奶、蛋類食品也可受此菌汙染。沙門氏菌食物中毒全年都可發生,吃了未煮透的病、死牲畜肉或在屠宰後其他環節汙染的牲畜肉是引起沙門氏菌食物中毒的最主要原因。有食品專家指出美國人吃雞蛋的習慣與國人不同,他們喜歡吃半熟的雞蛋甚至是生雞蛋,所以一旦雞蛋裡含有沙門氏菌,感染的機率就比較高。據統計,在世界各國的種類細菌性食物中毒中,沙門氏菌引起的食物中毒常列榜首。
由沙門氏菌引起的食品中毒症狀主要有噁心、嘔吐、腹痛、頭痛、畏寒和腹瀉等,還伴有乏力、肌肉痠痛、視覺模糊、中等程度發熱、躁動不安和嗜睡,持續時間2~3天,通常在發熱後72小時內會好轉。嬰兒、老年人、免疫功能低下的患者則可能因沙門氏菌進入血液而出現嚴重且危及生命的菌血症,少數還會合並腦膜炎或骨髓炎,平均致死率為4.1%。沙門氏菌在水中不易繁殖,但可生存2-3周,冰箱中可生存3-4個月,在自然環境的糞便中可存活1-2個月。沙門氏菌最適繁殖溫度為37℃,在20℃以上即能大量繁殖,因此,低溫儲存食品是一項重要預防措施。
我國國家衛生和計劃生育委員會於2013年釋出了《食品安全國家標準 食品中致病菌限量》(GB 29921-2013),在國標中分別對肉製品、水產製品、即食蛋製品、糧食製品、飲料、冷凍飲品、即食調味品等11類產品規定了沙門氏菌的限量要求,均為不得檢出。
二、金黃色葡萄球菌(需氧菌)
金黃色葡萄球菌(以下簡稱“金葡菌”),隸屬於葡萄球菌屬,是革蘭氏陽性菌代表,為一種常見的食源性致病微生物,廣泛存在於空氣、水、灰塵及人和動物的排洩物中。它是一種人獸共患病原菌,可導致人和動物的多種疾病,包括偽膜性腸炎、敗血症和膿毒症等,嚴重威脅人類和動物的生命安全。該菌最適宜生長溫度為37℃,pH為7.4,耐高鹽,可在鹽濃度接近10%的環境中生長。金葡菌常寄生於人和動物的面板、鼻腔、咽喉、腸胃、癰、化膿瘡口中,空氣、汙水等環境中也無處不在。
金葡菌廣泛存在於自然環境中。在適當的條件下,能夠產生腸毒素,引起食物中毒。近幾年,由其引發的食物中毒報道層出不窮,佔食源性微生物食物中毒事件的 25%左右,已成為僅次於沙門氏菌和副溶血性弧菌的第三大微生物致病菌。
《食品安全國家標準 食品中致病菌限量》(GB 29921-2013)制定了金葡菌的限量標準,規定熟肉製品、熟制水產品、熟制糧食製品等8大類食品中,同批次採集5份樣品,每份樣品中的金葡菌濃度均不得超出1000 CFU/g,僅允許其中1份樣品在100~1000 CFU/g之間。
三、副溶血性弧菌(兼性厭氧菌)

食源性致病菌,原來是你在搗亂 www.czprolab.com/news/4.html
副溶血性弧菌呈弧狀、桿狀、絲狀等多種形狀,無芽孢,是一種嗜鹽性細菌,是革蘭氏陰性桿菌。主要來源於海產品,如墨魚、海魚、海蝦、海蟹、海蜇,以及含鹽分較高的醃製食品,如鹹菜、醃肉等。其存活能力強,在抹布和砧板上能生存1個月以上,海水中可存活47天。此菌對酸敏感,在普通食醋中5分鐘即可殺死,對熱的抵抗力也較弱。
副溶血性弧菌食物中毒原因主要是烹調時未燒熟煮透或熟製品被汙染。人們食用被副溶血性弧菌汙染的食物後極可能會引起以腹痛(在臍部附近劇烈,多為陣發性絞痛)、腹瀉、噁心、嘔吐、發熱等為主要症狀的急性腸胃炎。潛伏期2~24小時,一般為10小時發病。其特徵之一為中毒者的糞便多呈水樣,且常混有粘液或膿血。此外,重症患者還可出現脫水、休克昏迷,少數病人可出現意識不清、痙攣、面色蒼白或發紺等現象,若搶救不及時,呈虛脫狀態,甚至可導致死亡,故副溶血性弧菌又有腸炎弧菌之稱。
在《食品安全國家標準 食品中致病菌限量》(GB 29921-2013)中制定了副溶血性弧菌的限量標準,規定水產製品、即食調味品中,同批次採集 5 份樣品,每份樣品中的副溶血性弧菌濃度均不得超出1000 MPN/g,僅允許其中1份樣品在100~1000 MPN/g之間。
四、阪崎腸桿菌(兼性厭氧菌)

食源性致病菌,原來是你在搗亂 www.czprolab.com/news/4.html
阪崎腸桿菌又叫黃色陰溝腸桿菌,直到1980年才被認為是一個新的菌種,並以日本微生物學家——Riichi Sakazakii的名字命名。它是一種周生鞭毛,能運動,比較常見的寄生在人和動物腸道內的無芽孢棒狀桿菌、革蘭氏陰性菌,其在一定的條件下可以使人或動物致病,因而被稱為條件致病菌。生長溫度為0~45 ℃,生長pH範圍5~10。
由於阪崎腸桿菌具有一定的耐熱、耐乾燥性,而且細胞外部有一層便於吸附於物體表面的特殊生物膜,使得該菌分佈較為廣泛,現已從奶粉(乳)製品、牛肉餡、香腸、乾酪、蔬菜、穀物類、豆腐、萵苣、藥草和調味料等分離出了該菌。
阪崎腸桿菌是一種食源性的條件致病菌,主要危害物件是免疫力低下的新生兒,由其引發的嬰兒、早產兒腦膜炎、敗血症及壞死性結腸炎散發和暴發的病例已在全球相繼出現,死亡率高達50% 以上。奶粉中的阪崎腸桿菌和沙門氏菌等是導致嬰幼兒感染、疾病和死亡的主要原因。
五、單核細胞增生李斯特氏菌(兼性厭氧菌)
食源性致病菌,原來是你在搗亂 www.czprolab.com/news/4.html
單核細胞增生李斯特氏菌(以下簡稱單增李斯特菌)是由一位名叫“約瑟夫·李斯特”的外國醫生髮現的。主要特徵之一是可在低溫下生長,0~45℃都能生存,在零下20℃的環境下仍能存活1年,在冰箱冷藏室4~6℃的溫度下仍可大量繁殖,所以就有“冰箱殺手”的稱號。
它在自然界分佈非常廣泛,土壤、糞便、水體、蔬菜、青貯飼料以及多種食品中都存在。單增李斯特菌屬於細胞內寄生致病菌,它自身不產生內毒素,而是產生一種具有溶血性質的外毒素——單增李斯特菌溶血素O(LLO),是其重要毒力因子。最容易汙染的食品為乳和乳製品、肉和肉製品、蔬菜、沙拉、海產品和冰淇淋等,尤其是冰箱中儲存時間過長的乳製品、肉製品最為常見。
由於體液免疫對單增李斯特菌感染無保護作用,故細胞免疫力低下和使用免疫抑制劑的患者容易受到它的感染。感染後的臨床症狀表現為:輕者為腹瀉、腹痛、發熱;重者可導致敗血症、腦膜炎和腦脊膜炎,孕婦可出現流產、死胎等後果,倖存的嬰兒則易患腦膜炎導致智力缺陷或死亡。
2010年釋出的乳製品安全標準及國家標準《食品安全國家標準 食品中致病菌限量》(GB 29921-2013)分別對乾酪、再製乾酪、熟肉製品以及即食生肉製品規定了單增李斯特菌的限量要求,均為不得檢出。









